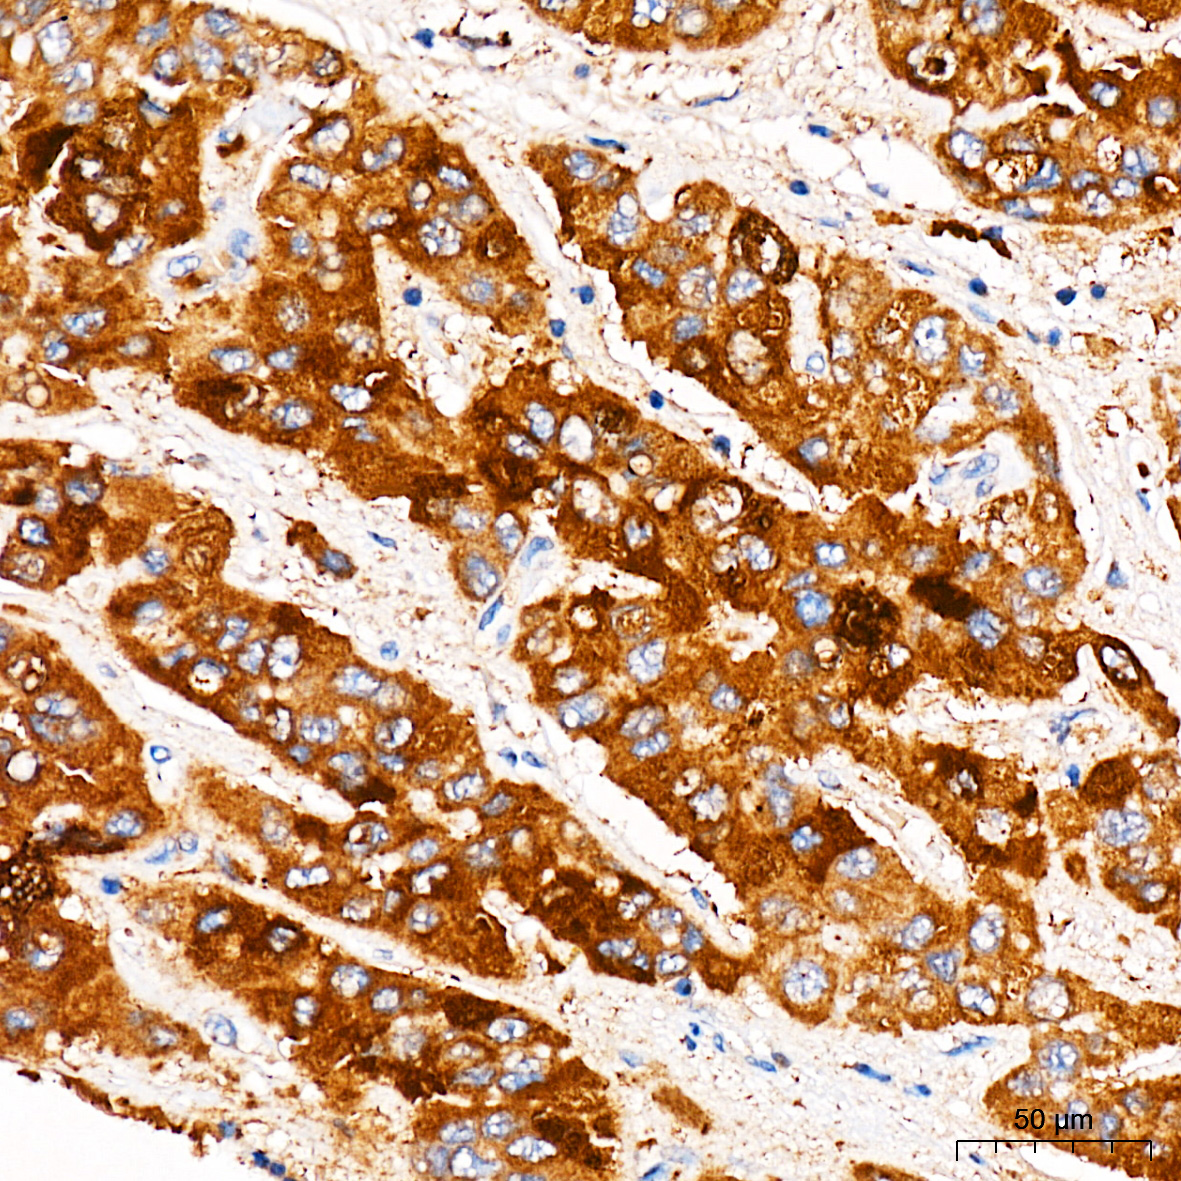

HMG-CoA reductase is the rate-limiting enzyme for cholesterol synthesis and is regulated via a negative feedback mechanism mediated by sterols and non-sterol metabolites derived from mevalonate, the product of the reaction catalyzed by reductase. Normally in mammalian cells this enzyme is suppressed by cholesterol derived from the internalization and degradation of low density lipoprotein (LDL) via the LDL receptor. Competitive inhibitors of the reductase induce the expression of LDL receptors in the liver, which in turn increases the catabolism of plasma LDL and lowers the plasma concentration of cholesterol, an important determinant of atherosclerosis. Alternatively spliced transcript variants encoding different isoforms have been found for this gene.
| Pack Size | 100ul, 1ml, 20ul |
|---|---|
| Applications | ELISA, IF/ICC, IHC-P |
| Host Species | Rabbit |
| Ig Isotype | IgG |
| Antibody Type | Polyclonal Antibody |
| Organism Species | Human |
| Concentration | – |
| Product Synonyms | HMGCR |
| Observed Mol Wt | 97kDa |
| Alternative Names | LDLCQ3; HMGCR |
| Immunogen (Antigen) | synthetic peptide |
| Format | Liquid |
| Buffer Formulation | 50% glycerol, PBS with 0.05% proclin300, pH7.3 |
| Reactivity | Human, Mouse |
| Uniprot ID | 3156 |
| Gene ID | P04035 |
| Purification | Antigen-specific affinity chromatography followed by Protein A affinity chromatography |
| Usage | For Research Use Only. Not for diagnostics or human use. |
| Shelf Life | 12 months at time of shipping |
| Shipping | Shipped in Dry Ice at -20 Degree Celsius |
| Storage | Store at -20 Degree Celsius. It is recommended to aliquot and store to avoid repeated freeze-thaw as it affects the stability of the antibody. |
| Research Areas | Cancer, Cell Biology, Immunology |
| KD/KO Validated | KD Validated |
| Disclaimer | The data indicated herein are as indicated and validated in our laboratory. These reagents are for research use only and not for in-vitro diagnostics or human use. |

![CAT1 Rabbit Polyclonal Antibody [KD Validated]](https://www.kinesisdx.com/wp-content/uploads/2025/05/A25422_N32165-5_WB_01-370x444.jpg)
![CYB5R3 Rabbit Polyclonal Antibody [KD Validated]](https://www.kinesisdx.com/wp-content/uploads/2025/05/A24755_N30496-4_WB_01-370x444.jpg)
![DIAPH1 Rabbit Polyclonal Antibody [KD Validated]](https://www.kinesisdx.com/wp-content/uploads/2025/05/A18081_N17470-4_KO-WB_01-370x444.jpg)
![EGFR Rabbit Polyclonal Antibody [KD Validated]](https://www.kinesisdx.com/wp-content/uploads/2025/05/A11082_N11999-5_WB_01-370x444.jpg)

![AARS2 Rabbit Polyclonal Antibody [KD Validated]](https://www.kinesisdx.com/wp-content/uploads/2025/05/A25997_N32217_WB_01-370x444.jpg)
Reviews
There are no reviews yet.